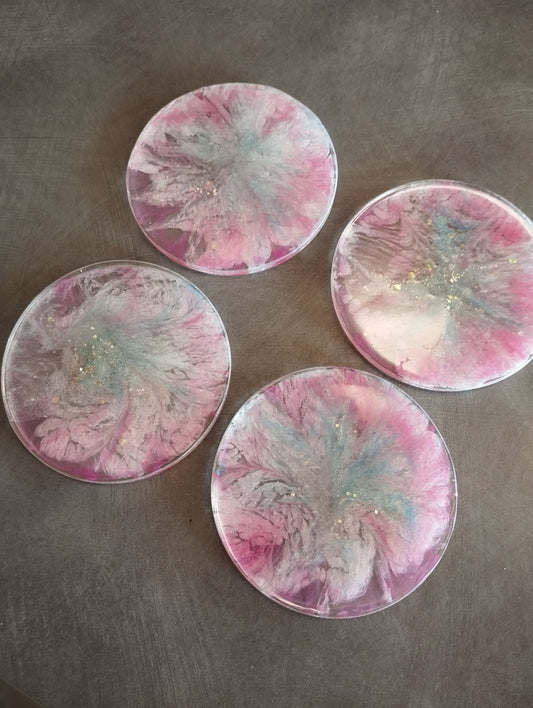
Dessous de verre en résine époxy

Featured products
-
Cendrier en résine époxy
Prix habituel €13,00 EURPrix habituelPrix promotionnel €13,00 EUR -
Charmant lézard décoratif en résine époxy
Prix habituel €12,00 EURPrix habituelPrix promotionnel €12,00 EUR -
Charmant porte clé ou accessoire de sac à main
Prix habituel €3,00 EURPrix habituelPrix promotionnel €3,00 EUR -
Chien en résine époxy
Prix habituel €8,00 EURPrix habituelPrix promotionnel €8,00 EUR -
Décoration chambre d'enfants
Prix habituel €8,00 EURPrix habituelPrix promotionnel €8,00 EUR -
Décoration pancarte chambre d'enfants
Prix habituel €11,00 EURPrix habituelPrix promotionnel €11,00 EUR -
Dessous de verre avec son rangement en résine époxy
Prix habituel €15,00 EURPrix habituelPrix promotionnel €15,00 EUR -
Dessous de verre en résine époxy
Prix habituel €7,00 EURPrix habituelPrix promotionnel €7,00 EUR